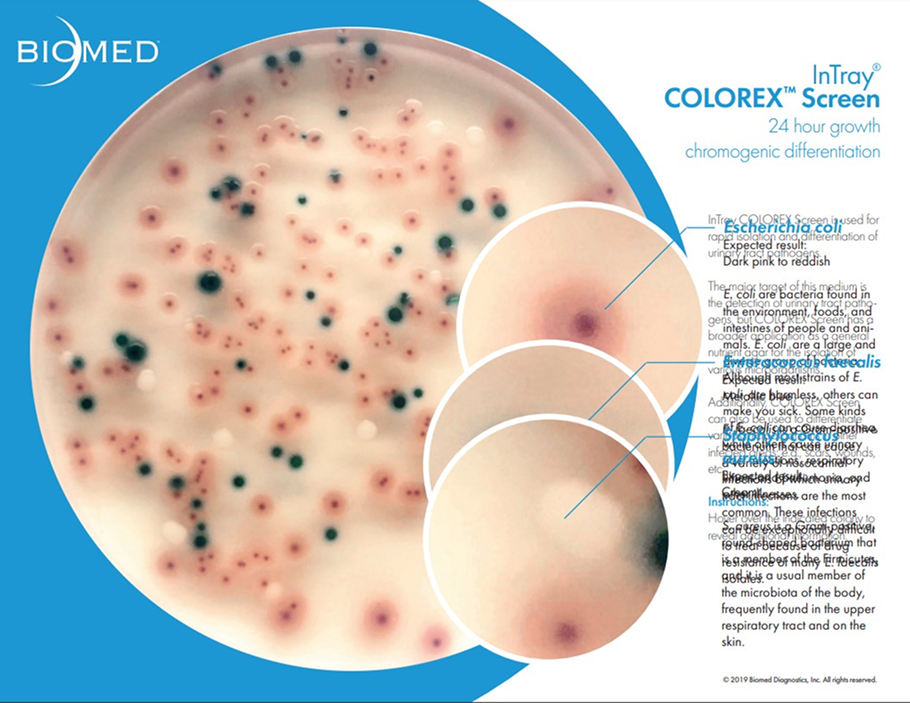
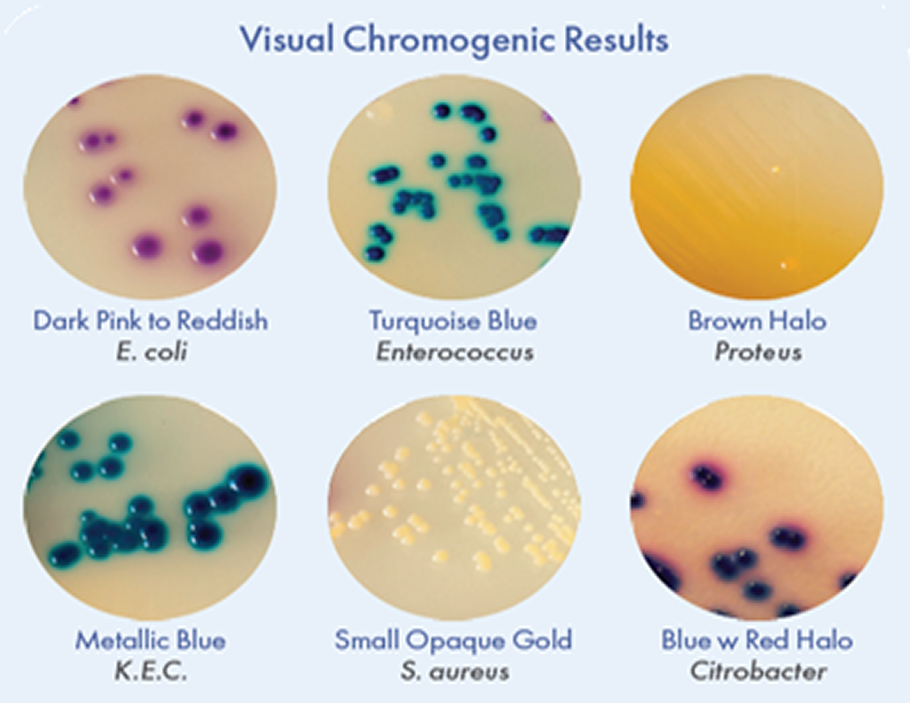

Тест для оцінки біоцинозу
InTray® COLOREX™ Screen
Тест InTray™ Colorex™ Screen забезпечує зростання, спостереження та хромогенну диференціацію окремих видів патогенних видів мікроорганізмів, що часто зустрічаються в сечовивідних шляхах, урогенітальному тракті, включаючи грампозитивні та грамнегативні бактерії.
Високоселективне живильне середовище у плашці, призначене для транспортування та інкубації зразків in vitro
- Тест InTray™ Colorex™Screen призначений для швидкого виділення та диференціації патогенних мікроорганізмів сечовивідних шляхів. Підходить для прямого посіву зразків сечі та іншого біоматеріалу.
- Демонструє високі ростові властивості для мікроорганізмів, стійких до внутрішньолікарняних інфекцій і з множинною лікарською резистентністю. (тому що містить певні антибіотики)
- Прямий посів біоматеріалу на плашку;
- Можливість використовувати індольний тест для E. coli ;
- TDA –тест для підтвердження Proteus на плашці;
- Мінімізує кількість лабораторних досліджень для оцінки біоценозу
- В одній плашці поєднані можливості транспортування, інкубації та «зчитування» результатів дослідження
Особливості даної системи
- Унікальна система тестів для оцінки біоценозу за одну маніпуляцію. Має низку переваг перед традиційним бак. посівом, даючи можливість побачити всі мікроорганізми, присутні в досліджуваному біоматеріалі через 20-24 години на одній плашці. Чутливість для E. coli становить 99,3%
Інкубація та облік результатів
- Інкубуйте при 37°C протягом 24-72 годин.
- Звертайте увагу на колонії будь-якого кольору та зміну морфології.
Транспортування та зберігання
- Зберігати в холодильнику, при температурі (2ºС-8ºС) Допускається зберігання при кімнатній температурі протягом одного дня.
- Уникайте заморожування та тривалого зберігання при температурі вище 40ºС.
- Не відкривайте тест до використання.
- Не використовуйте, якщо середовище пошкоджене або забруднене.
- Сеча;
- Еякулят;
- СПЖ;
- Урогенітальне відділення;
- Гній, кров, кал;
- Ексудат зі шкіряних вогнищ;
- Рубцева тканина;
Інтерпретація результатів
Escherichia coli – зміна кольору середовища на відтінки від темно-рожевого до червоного
Enterococcus species– змінює колір середовища на бірюзовий
Klebsiella, Enterobacter, Citrobacter– синій колір середовища, колонії з металевим блиском
Pseudomonas –колонії кремові, напівпрозорі
Proteus mirabilis– коричневий колір середовища, колонії з ореолом
Staphylococcus aureus– ідентифікується за наявності світло-жовтих, із золотистим відтінком непрозорих дрібних колоній
Staphylococcus saprophyticus– характеризується наявністю рожевих, маленьких, непрозорих колоній
1. Промаркуйте InTray перед використанням
2. Відігніть зовнішню етикетку InTray
3. Відсуньте та викиньте внутрішнє ущільнення
4. Зверніть зовнішню етикетку назад,
щоб вона приклеїлася до себе
5. Добре промийте зразок через високоселективне середовище
6. Переконайтеся, що етикетка натягнута,
і знову прикріпіть її до пристрою
7. Тепер InTray знову запечатаний і готовий
до інкубації, як зазначено
8. Помістіть лоток на столик мікроскопа
для спостереження
Висока якість продукції, що не має аналогів на ринку, рекомендована для використання ВООЗ (World Health Organization, WHO)

InPouch® TVВисокоспецифічний тест для культуральної діагностики урогенітального трихомоніазу.

InTray® GCВисокоспецифічна тест-система
для діагностики Neisseria gonorrhoeae.

InTray® DMСелективна культуральна тест-система
для діагностики грибкових захворювань.
Статті та офіційні документи
- Practical Bench Comparison of BBL CHROMagar Orientation and Standard Two-Plate Media for Urine Culture
John Merlino, Steven Siarakas, Graham Robertson, Glenn Funnell, Thomas Gottlieb, and Ross BradburyJ Clin Microbiol; 34.
- Evaluation of Use of a New Chromogenic Agar in Detection of Urinary Tract Pathogens
Z. Samra,M. Heifetz, J. Talmore, E. Bain, and J. BaharJOCM Vol 36, No 4
- Evaluation of CHROMagar Orientation for Differentiation and Presumptive Identification of Gram-Negative Bacilli and Enterococcus Species
Z. Samra,M. Heifetz, J. Talmore, E. Bain, and J. BaharJ Clin Microbiol; 34.
- A Study on Evaluation of Different Culture Media for the Isolation of Routine Urinary Pathogens
Biji, S. Manjusree, O. Sasikumari and J.T. Ramani Bai/h6>IJCM Vol 6 No 2
Офіційний та уповноважений представник в Україні
Рибакова Анастасія Анатоліївна
© Biomed Diagnostics, a DCN Dx Brand
Умови користування сайтом
Заповніть форму і ми обов'язково Вам передзвонимо!
Офіційний та уповноважений
представник в Україні
Рибакова Анастасія Анатоліївна
Facebook
Заповніть форму і ми обов'язково Вам передзвонимо!
© Biomed Diagnostics, a DCN Dx Brand